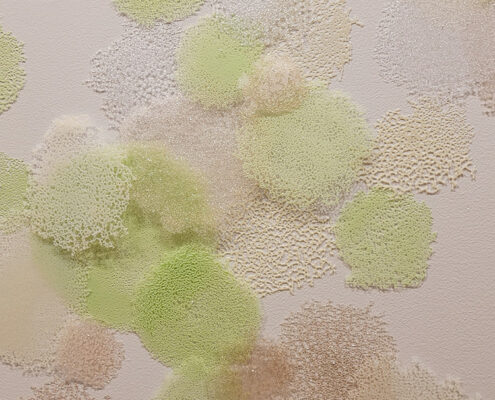
hiromi2

The Optics of Now: SoCal Glass (Installation view)
THE OPTICS OF NOW: SoCal Glass
JANUARY 27 – APRIL 13, 2024
Art Glass Sale: Saturday, April 6, 10am-4pm
Curator Gallery Talk: Saturday, March 30, 1-3pm
Palos Verdes Art Center / Beverly G. Alpay Center for Arts Education is pleased to present The Optics of Now: SoCal Glass, a survey of contemporary glass art curated by Emily Zaiden, Director and Curator of the Craft in America Center in Los Angeles.
Artists represented include Paul Brayton, Danielle Brensinger, Adam Gregory Cohen, Mariah Armstrong Conner, Alexander Dixon, Stephen Dee Edwards, Katherine Gray, Michael Hernandez, Eric Huebsch, John Gilbert Luebtow, Gregory Price, Sara Roller, Nicole Stahl, Amanda McDonald Stern, Ethan Stern, Susan Stinsmuehlen-Amend, Hiromi Takizawa, Kazuki Takizawa, Deshon Tyau, and Nao Yamamoto.
Read the story by Gail Phinney in the current issue of Southbay Magazine HERE.
Click on artists’ names below to see their pages with extended descriptions, bios, and more images.
Please scroll down to read curator’s statement.
PAUL BRAYTON, DANIELLE BRENSINGER, ADAM GREGORY COHEN, MARIAH ARMSTRONG CONNER, ALEXANDER DIXON, STEPHEN DEE EDWARDS, KATHERINE GRAY, MICHAEL HERNANDEZ, ERIC HUEBSCH, JOHN GILBERT LUEBTOW, GREGORY PRICE, SARA ROLLER, NICOLE STAHL, AMANDA MCDONALD STERN, ETHAN STERN, SUSAN STINSMUELEN-AMEND, HIROMI TAKIZAWA, KAZUKI TAKIZAWA, DESHON TYAU, NAO YAMAMOTO
CURATOR’S STATEMENT
It has been several years since an exhibition has highlighted the wildly vibrant, notably diverse, and tightly interconnected glass community in Southern California. This exhibition of approximately forty objects that vary in size and scale is a momentous celebration of the creative vitality that is emanating from the region. As California is well known for being a place driven by an inherent freedom from tradition, artists working here are known for taking their materials and skills to new ends. The desire to grow, stretch, and constantly evolve is organic to their approaches. What defines work here is the divergent and independent spirit of the makers who use the material to create form and figure, design, illusion, and meaning with a completely fresh take, untethered to preconceived notions and standards.
Glass has unique physical and optical properties that can only be experienced or perceived from numerous vantage points to be fully appreciated. Artists are able to skillfully manipulate these material characteristics to generate captivating artworks. In California, we are constantly in motion. The hum of our cars is a part of life. Mirroring that sense of mobility and movement, many of these works are intended to explore the possibilities of glass as a material that shiftsand mutates as the viewer circulates.
The region is a hub for artists who are at the forefront of cutting-edge and forward-leaping practices that stem from their solid foundations in both design and sculpture. In this sun-drenched, albeit increasingly hazy expanse, the unique quality of light also inspires participating artists for whom color and tone is fundamental. Other works are characterized by a reinterpretation of the fragility of the medium. Some objects appear almost ephemeral, althoughthe physical material has the ability to last for hundreds, if not thousands of years, as glass is one of the most ancient of craft materials.
A nuanced understanding of optics fuels the work of these artists. In our free-market dominated society, in politics, and other mainstream public spheres, optics now more commonly refers to how people and actions are perceived, and quite often, how perception can be manipulated to distort reality. Several pieces in the show use humor and metaphor to deal with how we see ourselves. The nature of the material offers the possibility for artists to play with illusion and to question what we see as truth.
The objects in this exhibition are a cross section of the wide ranging techniques and ideas that innovative artists are currently generating in the fluid, adaptable, and captivating medium of glass to reflect this day and age.
Emily Zaiden, Curator
Emily Zaiden is Director and Curator of the Craft in America Center in Los Angeles, where she has organized over seventy contemporary art, craft, and design exhibitions for the Center and partner museum venues since 2010. Zaiden oversees public programs, a K-12 education initiative, and digital projects, including the development of an online Craft Video Dictionary that will launch in 2024. She publishes exhibition catalogs, essays, and articles for journals and books including Archives of American Art Journal, American Tapestry Alliance, Metalsmith, Ettore Sottsass: Architect and Designer and Consuelo Jimenez Underwood: Art, Weaving, Vision. She has served as juror and lectured widely. Zaiden has an M.A. from the Winterthur Program in American Material Culture and has focused on craft processes, functional design, cultural art, and craft from a historical lens throughout her work. She was Research Associate to the Decorative Arts and Design department at LACMA and research editor for Architectural Digest prior to joining Craft in America.

![Deshaun-Tyau,-Object-011-[Pool-Balls],-2022](https://pvartcenter.org/2024/wp-content/uploads/2024/02/Deshaun-Tyau-Object-011-Pool-Balls-2022-495x400.jpg)



